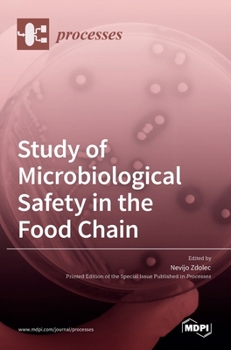
Hardcover Study of Microbiological Safety in the Food Chain Book

Study of Microbiological Safety in the Food Chain
Ensuring microbiological safety in the food (of animal origin) chain is a challenging task due to the complex interactions among animals, humans and the environment. However, technological and analytical advances in recent years have provided a broader insight into microbiological hazards in the food chain and risk assessment. The objective of the proposed Special Issue "Study of Microbiological Safety in the Food Chain" was therefore to obtain scientific papers addressing microbiological hazards in the food chain, such as bacterial antimicrobial resistance, bacterial or fungal spoilage of foods, the antimicrobial potential of the indigenous microbiota, the aminogenic or amine-reducing capacity of the microbiota, and papers that apply novel methods to study the food microbiome to discover potential, previously unknown microbial hazards. This Special Issue of the journal Processes entitled "Study of Microbiological Safety in the Food Chain" consists of nine research papers and one review paper. Four papers focus on the microbiological aspects of milk and dairy products, three on meat and meat products, two on eggs, and one on various market foods. The microorganisms of interest were species of lactobacilli, enterococci and molds, Yersinia enterocolitica, Bacillus cereus and the general microbiota in certain foods.
Related Subjects
Medical Medical Books Science Science & Math Science & Scientists Science & Technology